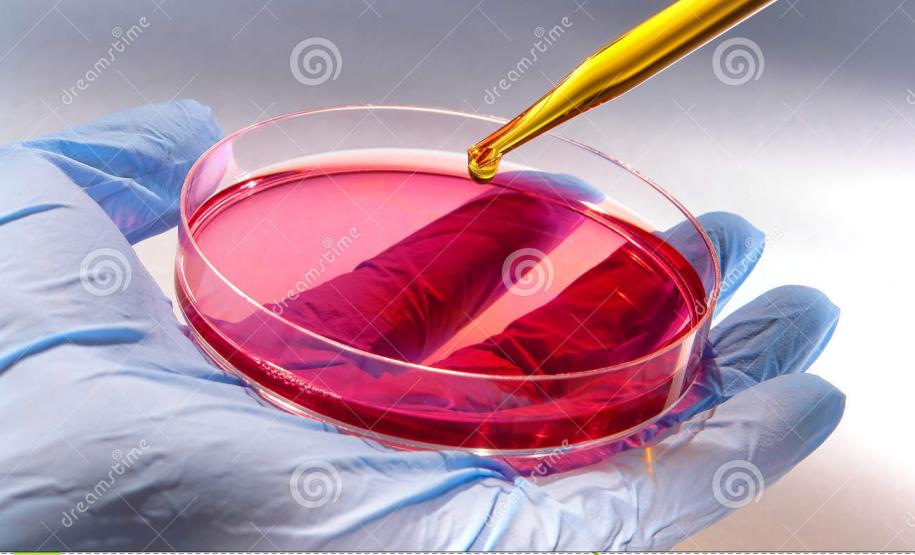
resultado resultado

Resultado referente à chamada pública nº 09, parceria entre a FA/Sanepar, é divulgado 01/12/2014 - 16:10

A Fundação Araucária e Sanepar selecionaram oito dos vinte e seis projetos submetidos na chamada pública nº 09 – referente ao Programa Paranaense de Pesquisas em Saneamento Ambiental. O Programa tem por objetivo apoiar atividades de pesquisa e desenvolvimento de instituições de ensino superior, institutos de pesquisa, associações ou sociedades técnico-científicas, públicas ou privadas, mediante a seleção de propostas.
Os projetos podiam englobar cinco linhas: água; esgoto; lixo; gestão de saneamento e reuso. O recurso total para financiamento é de R$ 1.000.000,00, sendo R$ 500.000,00 da Sanepar e R$ 500.000.00 da Fundação Araucária. A avaliação dos projetos foi feita em três fases: análise documental; análise de mérito e relevância científica e priorização das propostas aprovadas.
É o segundo ano que a Fundação Araucária firma parceria entre a instituição e a Companhia de Saneamento do Paraná – SANEPAR. “As nossas instituições de ensino vêm mostrando que estão cada vez mais qualificadas para o desenvolvimento de novas tecnologias e aperfeiçoamento e capacitação de pesquisadores. Com isso, temos o dever de criar condições para que o trabalho seja transformado em algo realmente útil para a sociedade”, afirmou a diretora científica da Fundação Araucária, Janesca Alban Roman.